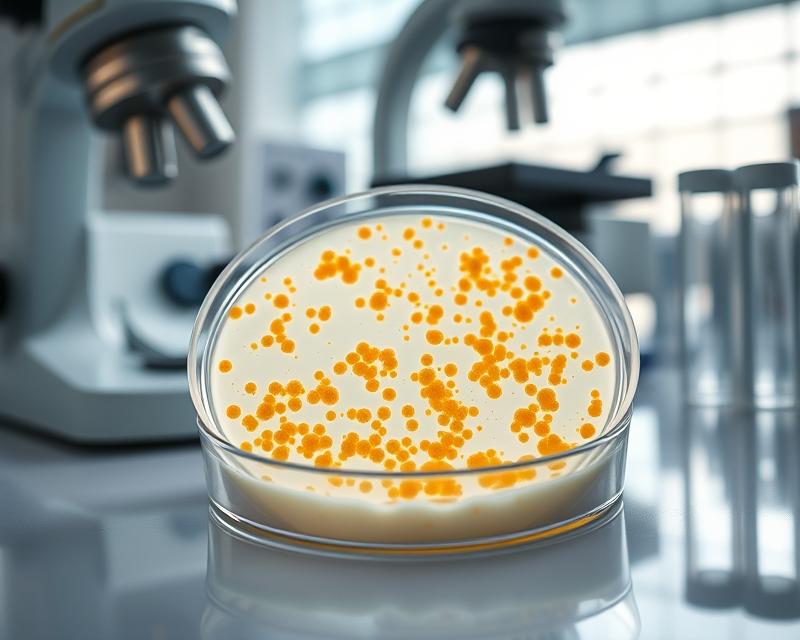

Gronkowiec, znany jako bakteria Staphylococcus, to mikroorganizm, który na stałe zasiedla nasz organizm, jednak jego obecność nie zawsze jest oznaką choroby. Wśród wielu gatunków tej bakterii, gronkowiec złocisty wyróżnia się jako jeden z głównych sprawców zakażeń bakteryjnych na świecie, mogąc prowadzić do poważnych i czasami zagrażających życiu chorób. Jego potencjał do wywoływania infekcji w sprzyjających warunkach sprawia, że zrozumienie mechanizmów zakażeń gronkowcowych oraz objawów z nimi związanych jest kluczowe dla naszej ochrony zdrowia. Z tego powodu warto przyjrzeć się bliżej temu, jak gronkowiec wpływa na nasze organizmy oraz jakie metody diagnostyki i leczenia mogą pomóc w walce z tym niebezpiecznym patogenem.
Gronkowiec choroba – co to jest?
Gronkowiec to rodzaj bakterii, które stanowią naturalną część flory bakteryjnej ludzi. Spośród 40 znanych gatunków gronkowca, 12 żyje w organizmach ludzkich. Najbardziej rozpowszechnionym jest gronkowiec złocisty (_Staphylococcus aureus_), który jest jedną z głównych przyczyn zakażeń bakteryjnych na świecie. Obecność gronkowca w organizmie nie zawsze wiąże się z chorobą, lecz w sprzyjających warunkach bakterie te mogą prowadzić do poważnych infekcji, zarówno miejscowych, jak i ogólnoustrojowych.
Grupując się w charakterystyczne „grona”, gronkowce są bakterami Gram-dodatnimi z rodziny Staphylococcaceae. W organizmie najczęściej występują trzy gatunki gronkowców:
- gronkowiec złocisty (_Staphylococcus aureus_),
- gronkowiec haemolyticus (_Staphylococcus haemolyticus_),
- gronkowiec epidermidis (_Staphylococcus epidermidis_).
Zakażenia gronkowcowe mogą występować na skórze, tkankach miękkich, a także w krwiobiegu, co prowadzi do różnorodnych objawów. Większość przypadków zakażeń gronkowca dotyczy ludzi z osłabionym układem odpornościowym, ale zdrowe osoby również mogą stać się nosicielami bakterii bez oznak choroby. Nosicielstwo gronkowca jest powszechne, co sprawia, że bakterie te są trudne do wyeliminowania z populacji. Znajomość gronkowca oraz sposobów jego przenoszenia jest kluczowa w zapobieganiu zakażeniom i ich skutkom zdrowotnym.
Jakie choroby wywołuje gronkowiec?
Gronkowiec, a zwłaszcza jego szczep złocisty, jest odpowiedzialny za szereg poważnych chorób, które mogą zagrażać życiu pacjentów. Wśród najczęstszych schorzeń wywoływanych przez zakażenie gronkowcem znajdują się:
- zapalenie wsierdzia – poważne zapalenie wewnętrznej wyściółki serca, które może prowadzić do uszkodzenia zastawek,
- zapalenie płuc – infekcja płuc, często wymagająca hospitalizacji,
- bakteriemia – obecność bakterii we krwi, co może prowadzić do sepsy,
- sepsa – zagrażający życiu stan zapalny organizmu, spowodowany infekcją,
- martwicze zapalenie powięzi – ciężka infekcja tkanek miękkich wymagająca natychmiastowego leczenia chirurgicznego,
- zakażenia skórne, takie jak czyraki i liszajec, które mogą występować w przypadku osłabienia odporności.
Choroby te są szczególnie niebezpieczne, zwłaszcza w kontekście osób z osłabionym układem odpornościowym lub pacjentów po wszczepieniach narządów. Gronkowiec złocisty wytwarza różnorodne toksyny, takie jak toksyna wstrząsu toksycznego i enterotoksyny, które dodatkowo potęgują ryzyko poważnych komplikacji zdrowotnych. Dobrze jest być świadomym objawów tych chorób, aby jak najszybciej szukać pomocy medycznej.
Jakie są objawy i powikłania zakażenia gronkowiecem?
Zakażenie gronkowcem może prowadzić do różnych objawów, które zależą od miejsca infekcji. Najczęściej występujące objawy to:
- wysoka gorączka,
- złe samopoczucie pacjenta,
- bolesne czyraki i ropnie,
- czerwone zabarwienie skóry,
- obecność ropnych wydzielin.
Gronkowiec złocisty, będący najczęstszym szczepem, wywołuje objawy głównie w formie zakażeń miejscowych, takich jak:
- czyraki,
- ropnie,
- liszajec,
- zapalenie gruczołów potowych.
W przypadku zakażeń ogólnoustrojowych, objawy mogą obejmować:
- wysoką gorączkę,
- osłabienie,
- silne stany zapalne w różnych narządach,
- zagrażające życiu powikłania, takie jak sepsa.
Sepsa jest szczególnie niebezpiecznym powikłaniem, które może wystąpić, gdy gronkowiec przemieszcza się z miejsca pierwotnego zakażenia do krwioobiegu. Ponadto, zakażenia gronkowiecem mogą prowadzić do:
- zapalenia płuc,
- zapalenia dróg moczowych,
- ostrej niewydolności wielonarządowej.
Właściwe badania bakteriologiczne są kluczowe dla postawienia diagnozy i skutecznego leczenia zakażeń gronkowcem, dlatego ważne jest, aby zwrócić uwagę na wszelkie niepokojące objawy.
Jak wygląda diagnostyka zakażeń gronkowcem i narażenie na zakażenie?
Diagnostyka zakażeń gronkowcowych opiera się na analizie objawów klinicznych oraz wyników badań mikrobiologicznych. Wykrycie obecności gronkowców w próbce jest kluczowe dla postawienia diagnozy.
Osoby szczególnie narażone na zakażenie to pacjenci z obniżoną odpornością oraz hospitalizowani pacjenci, którzy mogą być bardziej podatni na infekcje. Ponadto, gronkowiec może być przenoszony poprzez kontakt z osobą zakażoną, drogą kropelkową lub przez dotyk przedmiotów, z którymi miał kontakt.
W diagnostyce można wyróżnić kilka kluczowych metod:
- badania mikrobiologiczne, w tym posiewy, pozwalające na wykrycie gronkowców w próbkach krwi, moczu lub tkanek,
- analiza pokarmów w przypadku podejrzenia zatruć, co umożliwia wykrycie toksyn produkowanych przez szczepy gronkowca,
- badania tkankowe z podejrzanych obszarów ciała, które mogą ujawniać obecność bakterii.
Dokładna diagnostyka i odpowiednie badania bakteriologiczne są niezbędne do skutecznego zidentyfikowania źródła zakażenia oraz wdrożenia efektywnego leczenia.
Jakie są metody leczenia oraz zapobiegania zakażeniu gronkowcem?
Metody leczenia i zapobiegania zakażeniu gronkowcem obejmują przede wszystkim stosowanie odpowiednich antybiotyków oraz świadomość prozdrowotnych nawyków. Dzięki właściwie dobranym terapiom można skutecznie eliminować infekcje, jednak pojawiająca się oporność bakterii na leki stanowi istotne wyzwanie.
W leczeniu zakażeń gronkowcowych, lekarze najczęściej zalecają:
- stosowanie antybiotyków, które mogą być podawane miejscowo, doustnie lub dożylnie,
- w przypadku poważnych zakażeń — chirurgiczne oczyszczenie rany i usunięcie zakażonej tkanki.
Wybór konkretnego antybiotyku zależy od nasilenia infekcji oraz oporności bakterii na dostępne leki. Warto zaznaczyć, że w przypadkach zakażeń związanych z protezami, leczenie za pomocą antybiotyków często okazuje się nieskuteczne, co może wymagać interwencji chirurgicznej.
Zapobieganie zakażeniu gronkowcem jest równie istotne. Oto kluczowe zasady, które warto stosować:
- regularne mycie rąk,
- unikanie kontaktu z osobami zakażonymi,
- dezynfekcja przedmiotów codziennego użytku,
- szczególna ostrożność w przypadku osób z osłabioną odpornością.
Pamiętaj, że dbałość o higienę oraz zdrowie może znacząco zmniejszyć ryzyko zakażeń gronkowcem i innych chorób.
Więcej informacji na temat znajdziesz na stronie gronkowiec choroba.